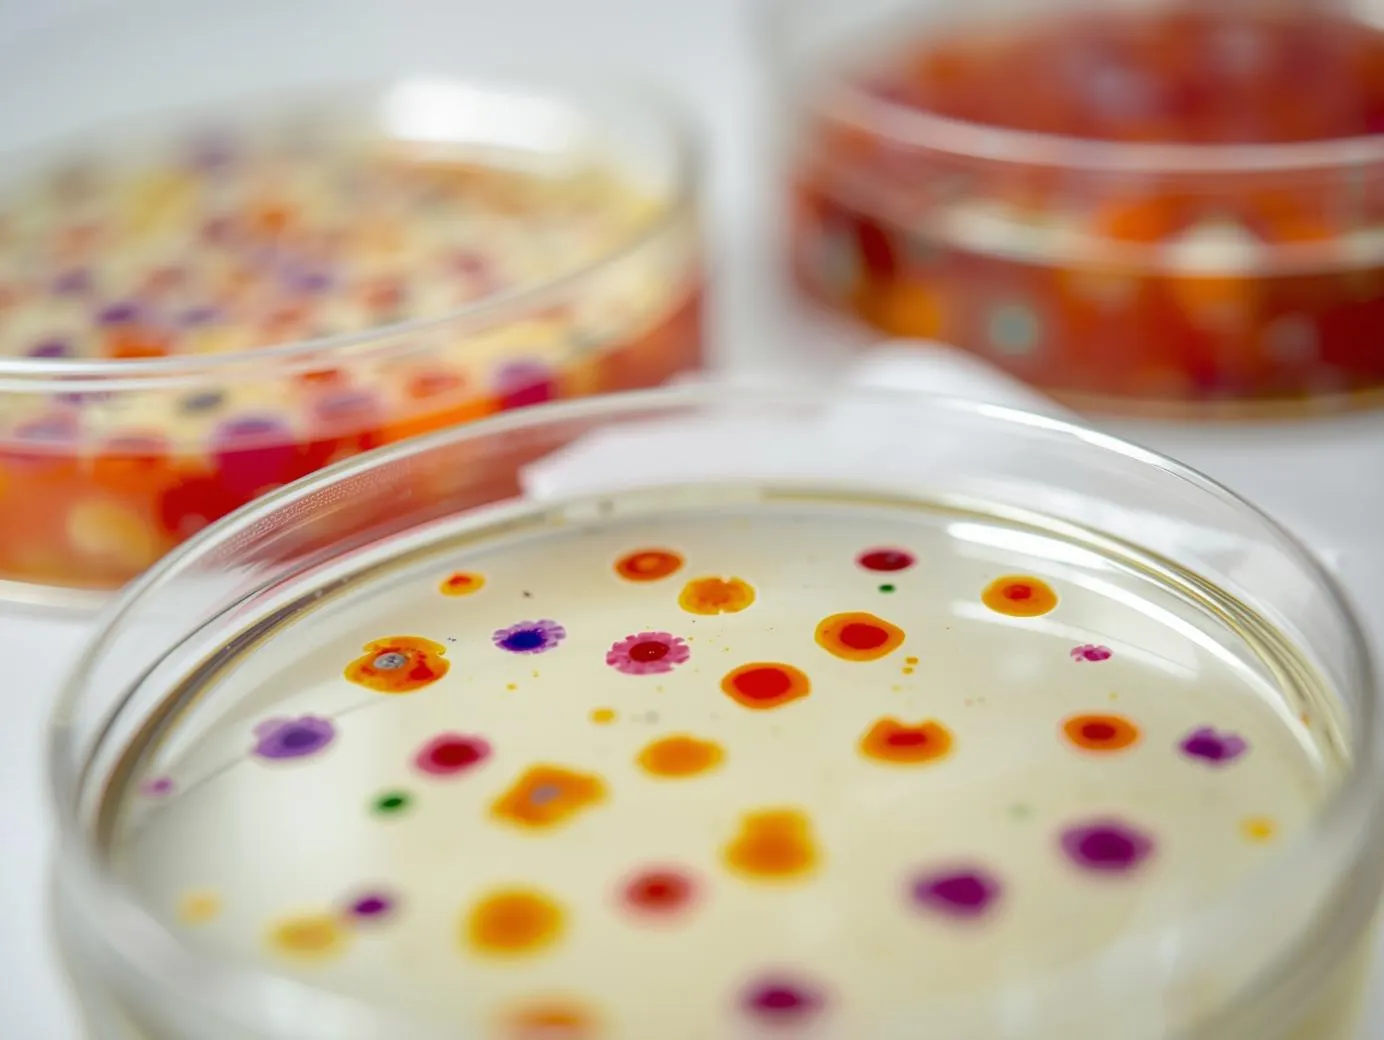
Coliform Testing
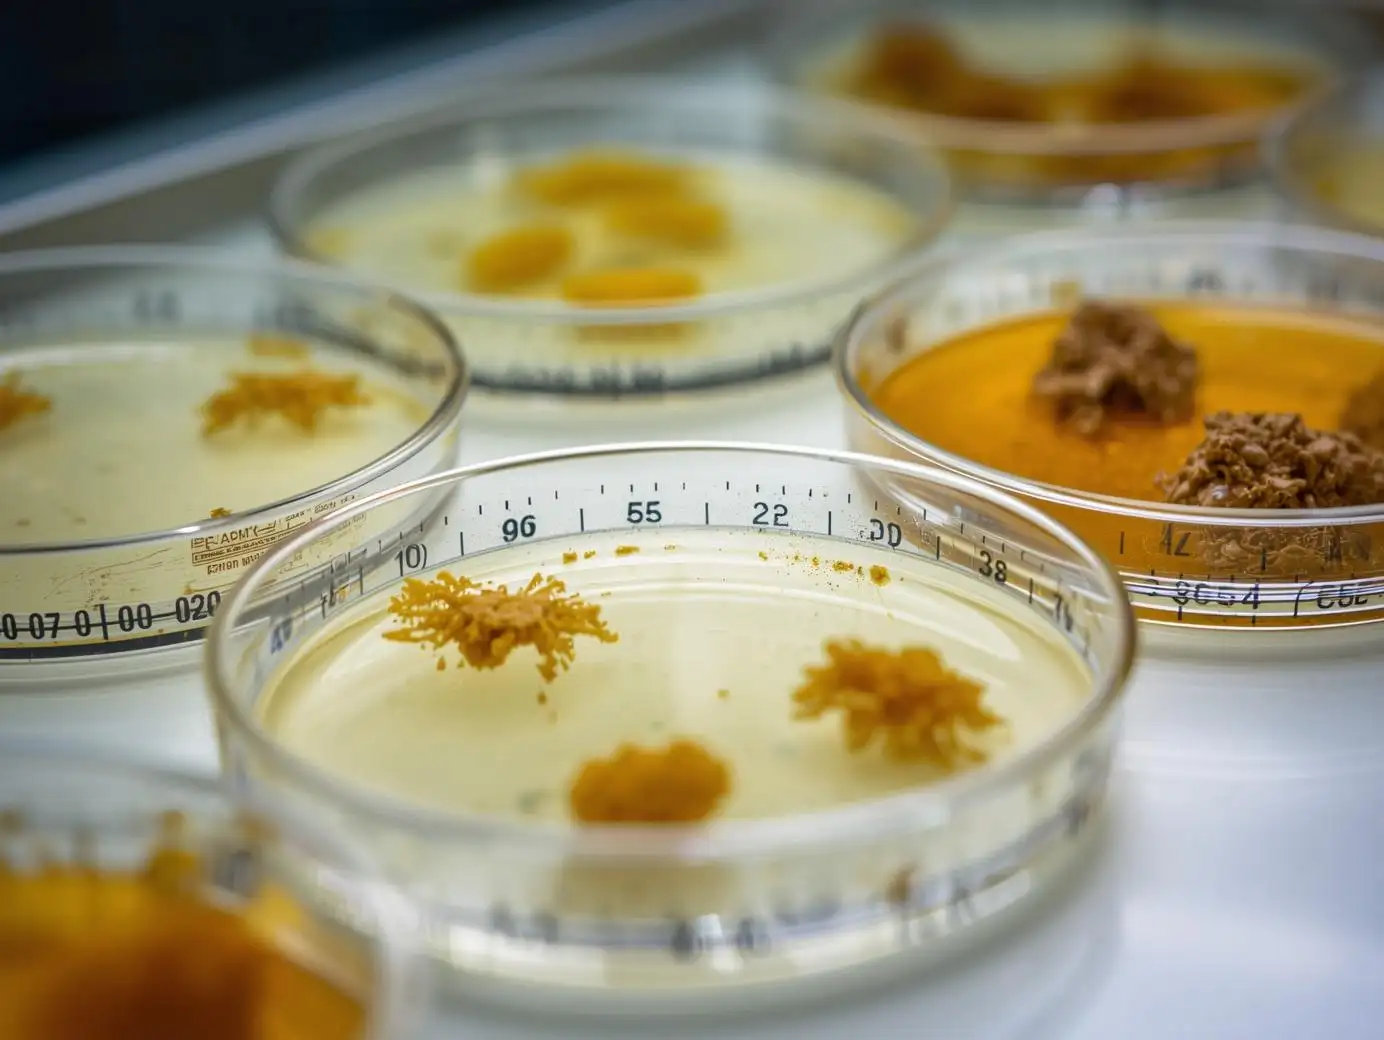
Yeast and Mold

Microbiological Food
Hygiene Testing
From Aerobic Plate Count to E. coli, our microbiological food hygiene testing transforms raw samples into actionable hygiene-monitoring intelligence using FDA LAAF-recognized and AOAC-validated methods.
Our Mission: Reliable Microbiological Food Hygiene Testing
In an industry where a single recall can devastate a reputation, certainty is your most valuable asset. AGT Food Labs delivers microbiological food hygiene testing through FDA LAAF-recognized methodology and AOAC-validated indicator-organism enumeration. From routine sanitation monitoring (APC) to fecal-indicator screening (E. coli) and spoilage-organism profiling (Yeast & Mold, Lactic Acid Bacteria), our facility produces the data that anchors your FSMA Food Safety Plan.
Scope note: Our PJLA ISO/IEC 17025:2017 accreditation (Cert L24-482-R2) covers chemistry methods (heavy metals, pesticides, water activity, pH, peroxide value, FFA, titratable acidity). Microbiological methods are not currently within that PJLA scope. AGT performs microbiological food hygiene testing under FDA LAAF Recognition using AOAC-validated rapid methods (Petrifilm™, Compact Dry); when an ISO/IEC 17025 accredited Certificate of Analysis is required for a specific micro panel, we coordinate testing with our accredited partner laboratory network and consolidate results into a single report.
Microbiological Food Hygiene Testing Services
Indicator-organism enumeration for FSMA compliance and quality assurance — APC, Coliforms, E. coli, Yeast & Mold, and Lactic Acid Bacteria via FDA LAAF-recognized AOAC-validated commercial methods.

Aerobic Plate Count (APC)
The Aerobic Plate Count enumerates mesophilic bacteria growing in aerobic conditions and serves as the primary gauge of total bacterial load in a sample. Elevated APC results commonly indicate temperature abuse upstream in the supply chain or sanitation breakdowns on the production line.
- AOAC 990.12 (Petrifilm™)
- AOAC 2015.13 (Rapid)
Sample Size: 100g minimum | LOD: < 10 CFU/g | Shipping: Refrigerated (2–8°C)
Industry Application:Used universally across meat, dairy, produce, and prepared-foods sectors to set baseline quality specifications and predict remaining shelf-life.
Coliform Count
Coliforms are environmentally widespread bacteria that are easily destroyed by heat. Their presence in a pasteurized product is a definitive sign of post-processing contamination — making coliform enumeration a cornerstone of microbiological food hygiene testing for dairy, beverages, and ready-to-eat foods.
- AOAC 991.14 (Petrifilm™)
- FDA BAM Ch. 4 (MPN)
Sample Size: 100g or 1 environmental swab | LOD: < 10 CFU/g | Shipping: Refrigerated
Industry Application:Critical for dairy pasteurization verification, water quality monitoring, and sanitation effectiveness checks on food-contact surfaces.

E. coli (Generic)
Generic Escherichia coli is the subset of the coliform group that originates exclusively from the gut. Unlike total coliforms, E. coli enumeration provides a direct fecal-contamination signal — a positive result raises the probability that pathogens like Salmonella may also be present and triggers a deeper investigation.
- AOAC 991.14 (Petrifilm™)
- AOAC RI 110402 (Compact Dry)
Sample Size: 100g or 1 environmental swab | LOD: < 10 CFU/g | Shipping: Refrigerated
Industry Application:Primary safety indicator in fresh produce, raw meats, and irrigation water. Often configured as a critical control point (CCP) in HACCP plans.
Yeast & Mold
Fungi thrive in conditions where bacteria struggle — low water activity, low pH, high sugar. Our Yeast & Mold enumeration screens these spoilage organisms to protect product quality in dried, acidic, and reduced-Aw matrices, with rapid 48-hour AOAC-validated readouts.
- AOAC 997.02 (Petrifilm™)
- AOAC 2014.05 (Rapid)
Sample Size: 100g | LOD: < 10 CFU/g | Shipping: Ambient or Refrigerated (do not freeze)
Industry Application:Essential for bakery shelf-life, dairy spoilage control (cheese, yogurt), dried fruit, and acidic sauces. Pair with a water-activity / pH study for full spoilage risk modeling.

Lactic Acid Bacteria (LAB)
Lactic Acid Bacteria can be beneficial (in fermented dairy and pickles) or destructive (in vacuum-packed meats and dressings). Targeted LAB enumeration detects these facultative anaerobes that standard aerobic counts miss — a key piece of microbiological food hygiene testing for processed-meat, dressing, and acidified-product manufacturers.
- AOAC 990.12 (modified aerobic count)
- MRS Broth enrichment
Sample Size: 100g | LOD: < 10 CFU/g | Shipping: Refrigerated (2–8°C)
Industry Application:Crucial for processed meats (hot dogs, deli slices), salad dressings, and shelf-stable acidified products. Pair with pH and water activity data for full spoilage modeling.
Industries Using Our Microbiological Food Hygiene Testing
Microbiological food hygiene testing programs supporting US food and beverage manufacturers across every major vertical.

Bakery

Dairy

Meat & Poultry

Produce

Water

Environmental
Why Choose AGT Food Labs?
Microbiological food hygiene testing with technical rigor and the agility of a dedicated safety partner.
Recognized under the FDA Laboratory Accreditation for Analyses of Foods program; ISO 17025 partner network handles accredited cert reporting on request.
24-hour rapid turnaround for APC, Coliforms, and E. coli; 48–72 hours for Yeast & Mold (incubation-bound).
Direct access to technical managers for result interpretation, root-cause work, and HACCP integration.
Common Questions About Microbiological Food Hygiene Testing
Is AGT's microbiological food hygiene testing PJLA-accredited?
What does Aerobic Plate Count (APC) indicate in food testing?
Why are Coliforms and E. coli tested separately?
What are acceptable limits for Yeast and Mold in food?
Does a low APC result guarantee the food is safe?
How often should hygiene monitoring be performed?
What is the turnaround time for standard hygiene tests?
Related Safety & Stability Services
Move beyond hygiene indicators to full pathogen verification and shelf-life validation.
Listeria Detection
Environmental swabbing and product testing for Listeria spp. across the production environment.
Salmonella Screening
Rapid molecular screening and cultural confirmation for Salmonella in ingredients and finished goods.
Shelf Life Testing
Use your hygiene data to set "Best By" dates through real-time or accelerated stability studies.
Ensure Production Safety with Microbiological Food Hygiene Testing
Validate your sanitation protocols with FDA LAAF-recognized indicator-organism testing.
Request a Hygiene Quote